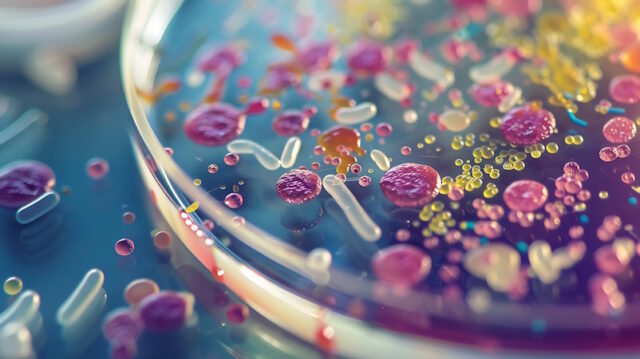

In 2024, the landscape of scientific research is shaped by a plethora of cutting-edge technologies. These tools are enhancing the precision, efficiency, and scope of scientific endeavors, allowing researchers to push the boundaries of knowledge and innovation. This article explores some of the most essential technologies that modern scientists rely on, highlighting their impact on various fields of research.
Advanced Microscopy Techniques
Microscopy remains a fundamental tool in scientific research, and recent advancements have significantly expanded its capabilities. Super-resolution microscopy, for instance, allows scientists to visualize structures at the nanometer scale, far surpassing the limitations of conventional light microscopy.
Techniques such as STED (Stimulated Emission Depletion) and PALM (Photoactivated Localization Microscopy) enable the detailed study of cellular and molecular processes in unprecedented detail.
Moreover, the integration of AI with microscopy is revolutionizing the field. AI algorithms can analyze complex imaging data, identify patterns, and even predict biological behaviors, making microscopy an even more powerful tool for discovery. According to a Nature article, these advancements are facilitating breakthroughs in cell biology, neurobiology, and materials science.
CRISPR and Gene Editing Technologies
CRISPR-Cas9 has transformed genetic research by providing a precise and efficient method for editing genes. This technology allows scientists to make targeted modifications to an organism’s DNA, enabling advancements in fields such as medicine, agriculture, and environmental science. In 2024, new variants of CRISPR technology, such as base editors and prime editors, offer even greater specificity and versatility, expanding the potential applications of gene editing.
CRISPR is being used to develop therapies for genetic disorders, improve crop resilience, and study gene functions in various organisms. The ability to edit genes with high precision is accelerating the pace of research and opening new avenues for scientific exploration.
Proteomic Analysis Services
Proteomics, the large-scale study of proteins, is crucial for understanding biological systems and disease mechanisms. Advanced proteomic analysis techniques allow scientists to identify and quantify proteins, study their interactions, and understand their functions within the context of complex biological networks.
A proteomic analysis service offers comprehensive solutions for proteomic research. These services provide researchers with access to state-of-the-art technology and expertise, enabling detailed analysis of protein samples. By leveraging such services, scientists can gain deeper insights into cellular processes, disease progression, and potential therapeutic targets.
Artificial Intelligence and Machine Learning
AI and machine learning are transforming scientific research by enabling the analysis of vast datasets, identifying complex patterns, and generating predictive models. These technologies are particularly valuable in fields such as drug discovery, where they can accelerate the identification of potential therapeutic compounds and optimize clinical trial designs.
Machine learning algorithms are also enhancing the design and optimization of experiments. By analyzing previous experimental data, these algorithms can suggest optimal conditions and predict outcomes, reducing the reliance on trial-and-error approaches. This capability is essential for research areas like materials science and systems biology, where experimental complexity can be overwhelming.
A notable development in AI-driven research is the use of AI platforms for personalized medicine. These platforms integrate genomic, clinical, and lifestyle data to create tailored treatment plans for individual patients, improving the efficacy and safety of medical interventions. A recent Wall Street Journal article discusses how AI is revolutionizing healthcare by enabling more precise and personalized treatment strategies.
Collaborative Platforms and Data Sharing
The rise of collaborative platforms and data-sharing initiatives is fostering greater collaboration and transparency in scientific research. Online platforms like the Open Science Framework and ResearchGate allow researchers to share their data, methodologies, and findings with the global scientific community. This openness accelerates the dissemination of knowledge and enables reproducibility, a cornerstone of scientific integrity.
Blockchain technology is also being explored as a means of ensuring the integrity and traceability of scientific data. By providing a decentralized and tamper-proof record of research activities, blockchain can enhance trust in scientific findings and facilitate collaboration across institutions and disciplines.
Wearable Technology and Real-Time Monitoring
Wearable technology is becoming increasingly sophisticated, offering new opportunities for real-time monitoring of physiological and environmental parameters. Devices such as smartwatches, fitness trackers, and biosensors can collect continuous data on heart rate, activity levels, glucose levels, and more. This data is invaluable for research in fields such as physiology, epidemiology, and personalized medicine.
In clinical trials, wearable devices are being used to gather real-time data on participants, providing insights into the efficacy and safety of interventions. This approach allows for more dynamic and comprehensive monitoring of trial outcomes, ultimately improving the quality of clinical research.
3D Printing and Bioprinting
3D printing technology is revolutionizing the creation of complex structures, from customized lab equipment to tissue engineering scaffolds. In 2024, bioprinting, a subset of 3D printing, is making significant strides by enabling the fabrication of biological tissues and organs. This technology holds the potential to transform regenerative medicine and transplantology by providing personalized tissue grafts and organ replacements.
Researchers are using bioprinting to create models of human tissues for drug testing and disease modeling. These models provide more accurate and reliable results compared to traditional animal models, enhancing the development of new therapies and reducing the need for animal testing.
Robotics and Automation
Robotics and automation are streamlining laboratory workflows, increasing efficiency, and reducing human error. Automated systems can handle repetitive tasks such as sample preparation, pipetting, and data analysis, freeing up researchers to focus on more complex and creative aspects of their work.
In high-throughput screening, robotic systems can process thousands of samples in a fraction of the time it would take manually. This capability is essential for large-scale studies and drug discovery projects where speed and accuracy are critical.
The essential technologies for modern scientists in 2024 are revolutionizing research across various fields. Advanced microscopy, gene editing, proteomic analysis, AI, collaborative platforms, wearable technology, 3D printing, and robotics are enhancing the precision, efficiency, and scope of scientific endeavors. By leveraging these cutting-edge tools, researchers can push the boundaries of knowledge, accelerate discoveries, and ultimately improve human health and well-being.
Disclaimer
The information contained in South Florida Reporter is for general information purposes only.
The South Florida Reporter assumes no responsibility for errors or omissions in the contents of the Service.
In no event shall the South Florida Reporter be liable for any special, direct, indirect, consequential, or incidental damages or any damages whatsoever, whether in an action of contract, negligence or other tort, arising out of or in connection with the use of the Service or the contents of the Service. The Company reserves the right to make additions, deletions, or modifications to the contents of the Service at any time without prior notice.
The Company does not warrant that the Service is free of viruses or other harmful components